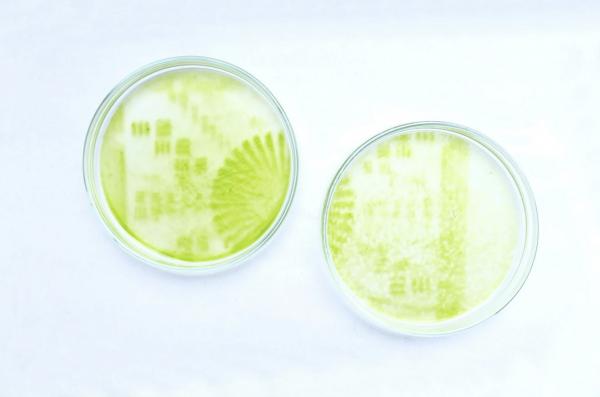
制作植物形状的日历,关于植物做成的日历

「DESIGN365 设计日历」是设计癖推出的一个新栏目,每天介绍一款好设计,帮你发现好设计,启发你的灵感。
打印机是我们工作学习中常见的东西
平时用来打印个文件啊
也有一些有有趣灵魂的人
会爱打印奇奇妙妙的东西
例如猫爪等物品
但是
你见过可以打印植物的打印机吗?

设计师 Luis Undritz 设计了一款打印机
并在米兰设计周上展出
它被定义为植物打印
通过将光投射到藻类上可以产生图像
从原理来讲
通过使用配备圆形数字光处理激光投影仪进行工作
或者可以这样理解
这个打印机是圆形的

黑白负片以数字方式送入打印机
然后将其投影到位于下方的一个小块材料的表面
然后印花到其他布料或者纺织物上
除了植物之外
其他动物也是可以的

在设计师看来
她希望未来创造一件有生命的服装
目前这个项目还只是在小规模的运营

这个创意很巧妙
也很有意义
图片:dezeen